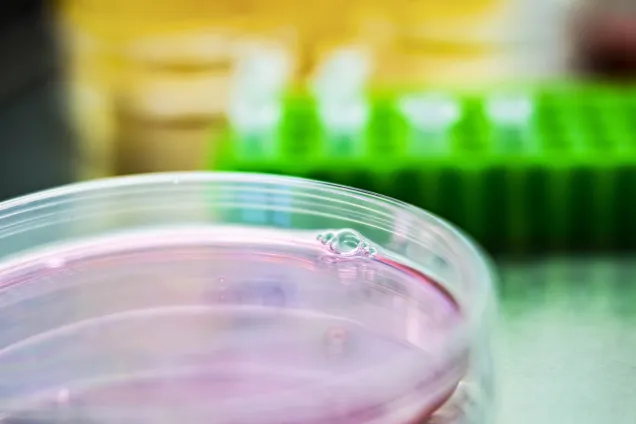
Close up photo of a petri dish.

Calendar
Upcoming events
21 November 2025 13:00 to 14:00 | WorkshopLocation: Online in ZoomYour h-index and your citations: Check your numbers and increase your visibility
21 November 2025 14:00 to 15:00 | SeminarLocation: On zoom, https://lu-se.zoom.us/j/64158479697EXODIAB webinar
26 November 2025 09:00 to 20:00 |Location: First Hotel Planetstaden, Dalbyvägen 38, 224 60 Lund, SverigeFoundHer Bootcamp – Let’s redefine the entrepreneurial narrative together!
26 November 2025 13:30 to 15:00 | Seminar, Career/KarriärLocation: BMC A10, SegerfalksalenGrant Landscape in Sweden
2 December 2025 09:00 to 11:00 | Seminar, Career/KarriärLocation: BMC:E11075 (Snilleblixten), Sölvegatan 19, LundThe job behind the title: Life Science careers explained, and how to get there
2 December 2025 14:00 to 15:00 | SeminarLocation: Online in ZoomGet started with Covidence – a tool for literature reviews
3 December 2025 08:30 to 16:00 | , Career/KarriärLocation: The Inspira building at Medicon Village. Entrance from Scheeletorget, Lund.Career Day | Life Science
4 December 2025 10:00 to 11:00 | OtherLocation: LU Innovations incubator-location. Floor 2, at X-Lab, Lund University's Makerspace. Kommunikationsvägen 5. More info on Location: https://www.x-lab.lth.se/about/how-to-find-us/Info-session & Q&A: Sten K Johnson Foundation grants
4 December 2025 15:00 to 16:00 | SeminarLocation: Segerfalksalen, BMC A10 | Sölvegatan 17, 223 62 LundStem Cell Stars Seminar - Understanding the human brain: from embryos to organoids and back again with Paola Arlotta
9 December 2025 08:30 to 17:00 | ConferenceLocation: AF-borgen, Sandgatan 2, 223 50 Lund, Sweden and onlineKnowledge for Sustainable Development 2025 - Breaking barriers to climate solutions
9 December 2025 10:00 to 11:30 | SeminarLocation: Segerfalksalen, BMC A10 | Sölvegatan 17, 223 62 LundLund Immuno Talk
10 December 2025 15:00 to 16:00 | SeminarLocation: Segerfalksalen, BMC A10 | Sölvegatan 17, 223 62 LundStem Cell Talk: Transposable elements and the human brain with Johan Jakobsson
10 December 2025 17:15 to 19:00 | OtherLocation: Kommunikationsvägen 5, LU Innovations incubator, VentureLabAfter Science Network
12 January 2026 09:00 to 16 January 2026 17:00 | OtherLocation: FACS Core Facility, BMC, Lund UniversityFlow Cytometry Sorting Course - MEFLCS1
2 February 2026 09:00 to 4 February 2026 17:00 | OtherLocation: FACS Core Facility, BMC, Lund UniversityFlow Cytometry Introductory Course - MEFLIN1
Halfway reviews
Get list of and invitations to upcoming halfway reviews in the Swedish calendar.
Thesis defence seminars
Get list of and invitations to upcoming thesis defence seminars in the Swedish calendar.
Publish in the calendar
Do you arrange an event and would like to publish it in the Intramed calendar?
Publish an event in the calendar on Intramed and other websites
Ongoing events

Open Call for Interdisciplinary PhD Research Project Proposals: RAMP-UP Doctoral Programme
Course: Handling, maintenance and understanding of human pluripotent stem cells
